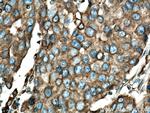
BAP31 Antibody in Immunohistochemistry (Paraffin) (IHC (P))

Search
Proteintech
BAP31 Polyclonal Antibody
{{$productOrderCtrl.translations['antibody.pdp.commerceCard.promotion.promotions']}}
{{$productOrderCtrl.translations['antibody.pdp.commerceCard.promotion.viewpromo']}}
{{$productOrderCtrl.translations['antibody.pdp.commerceCard.promotion.promocode']}}: {{promo.promoCode}} {{promo.promoTitle}} {{promo.promoDescription}}. {{$productOrderCtrl.translations['antibody.pdp.commerceCard.promotion.learnmore']}}
产品信息
11200-1-AP
种属反应
已发表种属
宿主/亚型
分类
类型
抗原
偶联物
形式
浓度
规格
纯化类型
保存液
内含物
保存条件
运输条件
产品详细信息
Immunogen sequence: MSLQWTAVA TFLYAEVFVV LLLCIPFISP KRWQKIFKSR LVELLVSYGN TFFVVLIVIL VLLVIDAVRE IREYDDVTEK VNLQNNPGAM EHFHMKLFRA QRNLYIAGFS LLLSFLLRRL VTLISQQATL LASNEAFKKQ AESASEAAKK YMEENDQLKK GAAVDGGKLD VGNAEVKLEE ENRSLKADLQ KLKDELASTK QKLEKAENQV LAMRKQSEGL TKEYDRLLEE HAKLQAAVDG PMDKKEE (1-246 aa encoded by BC014323)
靶标信息
BAP31 (B-Cell Receptor Associated Protein, 31-kDa) is a multiple membrane spanning protein of the endoplasmic reticulum. It has been shown to form both homo- and hetero-oligomers with the closely related BAP29, and is a potential apoptotic regulator as a predicted BCL-2/BCL-XL-associated protein. In the C-terminal domain of BAP31, there are two identical recognition sites for initiator Caspases 1 and 8 of the programmed death cascade. It is hypothesized that BAP31 plays a role in the transport of selected proteins to the Golgi apparatus. BAP31 has also been shown to control expression of CFTR (cystic fibrosis transmembrane conductance regulator). It is believed that interference with the expression or function of BAP31 in epithelial cells may be a way to circumvent the chloride channel defect in cystic fibrosis.
仅用于科研。不用于诊断过程。未经明确授权不得转售。
生物信息学
蛋白别名: 6C6 antigen; 6C6-AG tumor-associated antigen; accessory protein BAP31; B-cell receptor-associated protein 31; BCR-associated protein 31; BCR-associated protein Bap31; CDM protein; OTTHUMP00000025978; p28; p28 Bap31; Protein CDM; unnamed protein product
基因别名: 6C6-AG; BAP31; BCAP31; CDM; DDCH; DELXQ28; DXS1357E; MICRODELXq28
UniProt ID: (Human) P51572, (Mouse) Q61335
Entrez Gene ID: (Human) 10134, (Rat) 293852, (Mouse) 27061